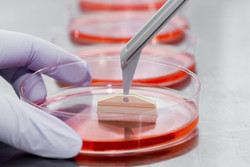

Favorire l'attecchimento delle cellule staminali
Un numero significativo di pazienti che trarrebbero vantaggio dal trapianto di midollo osseo o di cellule staminali ematopoietiche (HSCT) non può sottoporsi al trattamento, per la carenza di cellule di donatori. Un modo eccellente per ovviare a questo problema è il potenziamento dell'efficienza dell'attecchimento, che si verifica quando le nuove cellule deputate alla produzione del sangue iniziano a crescere e a funzionare correttamente, generando cellule staminali sanguigne sane. Il progetto HEMHOME ("Defining regulators of hematopoietic stem cell homing and engraftment") ha identificato nuove molecole che mediano l'homing e l'adesione delle cellule ematopoietiche progenitrici e staminali (HSPC) alla loro nicchia nel midollo osseo. Il microambiente che interagisce con le cellule staminali per regolare il destino cellulare è infatti denominato nicchia delle cellule staminali. I ricercatori sono riusciti a sviluppare un metodo di selezione basato su RNA breve a forcina (shRNA) per isolare possibili molecole deputate alla mediazione. La selezione ha dimostrato la fattibilità di questo approccio, poiché ha permesso di rilevare gli elementi regolatori già conosciuti dell'adesione delle HSPC. Una molecola promettente, non ancora studiata fino ad ora, è la citoesina 1 (CYTH1). La convalida della CYTH1 nelle interazioni della nicchia HSPC potrebbe farne il candidato ideale per modulare il processo di attecchimento nella prassi clinica. Utilizzando la microscopia IRM in collaborazione con il Dipartimento di immunologia dell'Università di Lund, il team ha analizzato esattamente in che modo la CYTH1 altera le proprietà di adesione delle HSPC. In particolare, gli scienziati hanno studiato lo stato di attivazione della CYTH1-integrina, che partecipa attivamente a interazione, homing e colonizzazione delle cellule e, grazie alla microscopia time-lapse, hanno analizzato il movimento delle HSPC con CYTH1, utilizzando stress casuale o di taglio. Nel contesto della medicina rigenerativa, la terapia basata sulle cellule staminali potrebbe configurarsi come elemento critico nell'assistenza sanitaria del futuro. Il progetto HEMHOME ha identificato e convalidato una molecola che potrebbe essere sviluppata per l'uso clinico nei trapianti di midollo osseo.